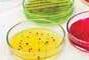
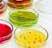

CORPORATE BROCHURES

INTRODUCTION









































































































Obstructive Sleep Apnoea (OSA)
Obstructive sleep apnoea (OSA) is a common condition affecting roughly 1 in 3 people. It is caused by the narrowing and collapsing of the upper airway during sleep. Surgery is one of the treatment options for OSA.

Surgery for Snoring and Obstructive Sleep Apnoea

How Can Surgery Help?
Surgery widens the upper airway space by:
• Reducing excess tissue
• Reducing collapsibility of tissue
What Are the Aims of Surgery?
Surgery can be done to:
Facilitate usage of the continuous positive airway pressure (CPAP) machine
• Improve snoring and sleep apnoea symptoms
Surgery Options for the Treatment of OSA
Common surgeries for OSA include (but are not limited to):
• Tonsillectomy
• Uvulopalatopharyngoplasty
• Septoplasty
Inferior turbinoplasty
• Radiofrequency inferior turbinate
• Adenoidectomy
• Radiofrequency of the palate/ tongue
• Coblation tongue channelling
• Robotic surgery
• Bony surgery Tracheostomy
What Should Expect If Undergo Surgery?
If you decide to undergo surgery, your surgeon will discuss with you as to which surgery is suitable for you. A combination of surgeries may be recommended for your snoring and sleep apnoea as this condition is often caused by obstructions at a few different levels in the upper airway.
Surgery aims to improve symptoms and alleviate your condition.
However, there can be some residual snoring, persistent symptoms or relapse of symptoms after surgery. This is because there are various other contributing factors including excess weight and muscle laxity that come with ageing, as well as family history predisposition.
Some patients may also need other complementary treatment after surgery. This may include weight loss, dental appliance, myofunctional therapy, use of continuous positive airway pressure (CPAP) therapy, treatment of nasal allergies, maintenance of sleep hygiene and having an active lifestyle, etc.
Different Types of Surgery for Snoring and Sleep Apnoea Tonsillectomy
This surgery removes both tonsils.


Radiofrequency inferior turbinate
This operation is also usually offered to patients with a blocked nasal airflow due to an enlarged inferior turbinate. Inferior turbinates are normal bones in our noses that are covered with soft tissue linings. When enlarged, they can reduce air passage within our noses.
The surgery involves using radiofrequency energy to generate thermal energy. This reduces the volume of the tissue swelling of the inferior turbinate, thus providing better nasal airflow. The operation can be done under local or general anaesthesia. There are no external cuts or scars.


of the soft palate/ tongue. This can help reduce the vibration and collapse of the soft palate/tongue. The operation can be done under local or general anaesthesia. There are no external cuts or scars.


Coblation tongue channelling This surgery uses coblation technology, which is bipolar radiofrequency energy, to reduce the volume of the tongue. It also stiffens the tongue to prevent it from flopping backwards and obstructing the upper airway. This is usually offered to patients with tongue enlargement or laxity causing the narrowing of the upper airway. The operation is done under general anaesthesia. There are no external cuts or scars.
Robotic surgery Advanced robotic

